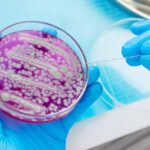

Projeto com inteligência artificial (IA) busca acelerar vacinas e tratamentos contra resistência a superbactérias.
Siga o Olhar Digital no Google Discover
Tudo sobre Inteligência Artificial
Pesquisadores do Reino Unido vão lançar um projeto de três anos que usa inteligência artificial (IA) para enfrentar o avanço das superbactérias resistentes a antibióticos. A iniciativa surge em meio ao aumento global da resistência antimicrobiana (AMR), fenômeno no qual bactérias e outros patógenos evoluem a ponto de driblar medicamentos existentes. O processo é acelerado pelo uso excessivo de antibióticos tanto na saúde quanto na agricultura, e já representa um risco crescente para sistemas de saúde em todo o mundo. As informações são do portal Euronews.
Segundo dados globais, cerca de um a cada seis casos laboratoriais de infecções bacterianas já apresenta resistência aos antibióticos. As projeções indicam ainda que a AMR pode causar diretamente 39 milhões de mortes até 2050, o que reforça a urgência por novas estratégias de combate. Agora, pesquisadores e empresas apostam na IA como aliada para acelerar a descoberta de tratamentos.

Como a IA pode atuar no combate às superbactérias
A iniciativa reúne cerca de 50 cientistas e começa no início do próximo ano, financiada com £45 milhões pela farmacêutica GSK. O projeto será desenvolvido em parceria com a Fleming Initiative, que integra pesquisadores, formuladores de políticas públicas e profissionais de saúde.
Responsáveis pelo programa afirmam que as infecções resistentes estão cada vez mais difíceis de tratar e representam um risco crescente para pacientes. O foco inicial estará em patógenos que a Organização Mundial da Saúde (OMS) considera prioritários, incluindo Aspergillus, bactérias Gram-negativas como Escherichia coli e Klebsiella pneumoniae, além de Staphylococcus aureus, com destaque para a variante resistente à meticilina (MRSA).
Um dos trabalhos principais será o desenvolvimento de um modelo de IA capaz de projetar e testar novos antibióticos contra infecções Gram-negativas multirresistentes. A GSK afirma que os dados gerados e os modelos de IA serão disponibilizados para pesquisadores de outros países com o objetivo de acelerar a criação de tratamentos de próxima geração.

Outro grupo de cientistas usará IA para investigar como o sistema imunológico reage ao S. aureus, o que pode ajudar no desenvolvimento de uma vacina eficaz.
O que o projeto promete entregar
- Modelos de IA para projetar e testar novos antibióticos;
- Compartilhamento global de dados para acelerar pesquisas;
- Estudos avançados sobre resposta imune ao S. aureus;
- Bases científicas para futuras vacinas contra superbactérias;
- Estratégias colaborativas entre indústria, ciência e saúde pública.

Para os líderes da iniciativa, apenas a união de especialistas e tecnologias avançadas permitirá desenvolver novos medicamentos e intervenções capazes de enfrentar superbactérias antes que elas se tornem incontroláveis.
Leia mais:
Colaboração para o Olhar Digital
Jornalista com mais de 13 anos de experiência, tenho faro pela audiência e verdadeira paixão em buscar alternativas mais assertivas para a entrega do conteúdo ao usuário.
Descubra mais sobre Euclides Diário
Assine para receber nossas notícias mais recentes por e-mail.